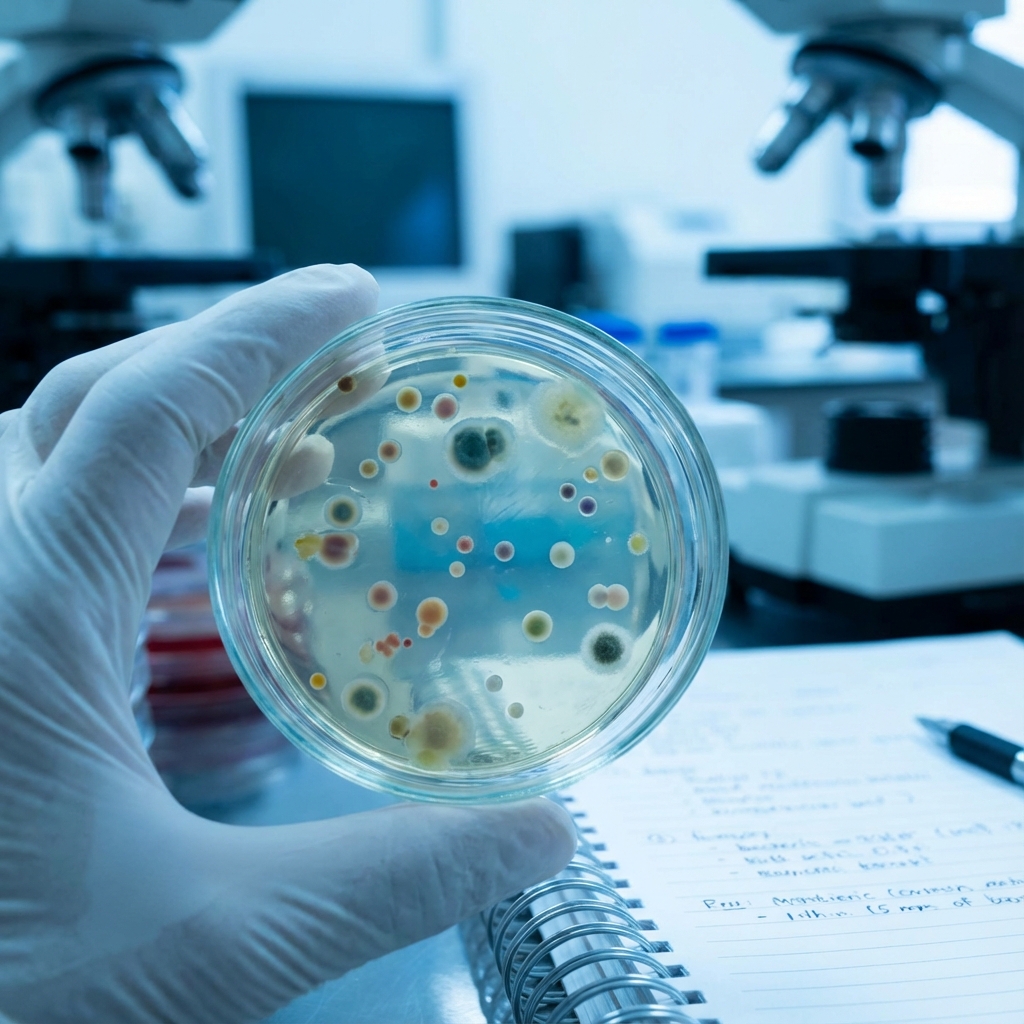
Genetic Research Collaboration

We maintain the highest standards of accuracy and precision in every test we perform.
Utilizing cutting-edge technology and modern methodologies for chemical and medical research.
Our focused approach ensures rapid turnaround times without compromising on quality.
Leading diagnostic center in Thailand providing high-quality reports using state-of-the-art laboratory equipment.

Expert analysis of tissues and fluids for accurate disease diagnosis and staging.
Comprehensive DNA sequencing and genetic counseling for hereditary conditions.
Identification of bacterial, viral, and fungal pathogens with drug sensitivity testing.
We pride ourselves on building long-lasting relationships with healthcare providers through reliability and excellence.
"V-TECH has been our primary diagnostic partner for over 5 years. Their accuracy and turnaround time are unmatched in the region. We trust them with our most critical cases."
"The level of professionalism and the quality of reports we receive from V-TECH is exceptional. Their online portal makes tracking results incredibly easy for our staff."
"As a research laboratory, we require absolute precision. V-TECH's commitment to international standards gave us the confidence we needed for our clinical trials."
Our clinical laboratory is accredited by international standards, providing reliable results to over 100 partner clinics and hospitals across the country.


Learn about the essential laboratory best practices that ensure accuracy, safety, and efficiency in scientific research.

Discover the latest advancements in pathological testing and how they're revolutionizing disease diagnosis.

Explore emerging trends and technologies shaping the future of medical laboratories worldwide.